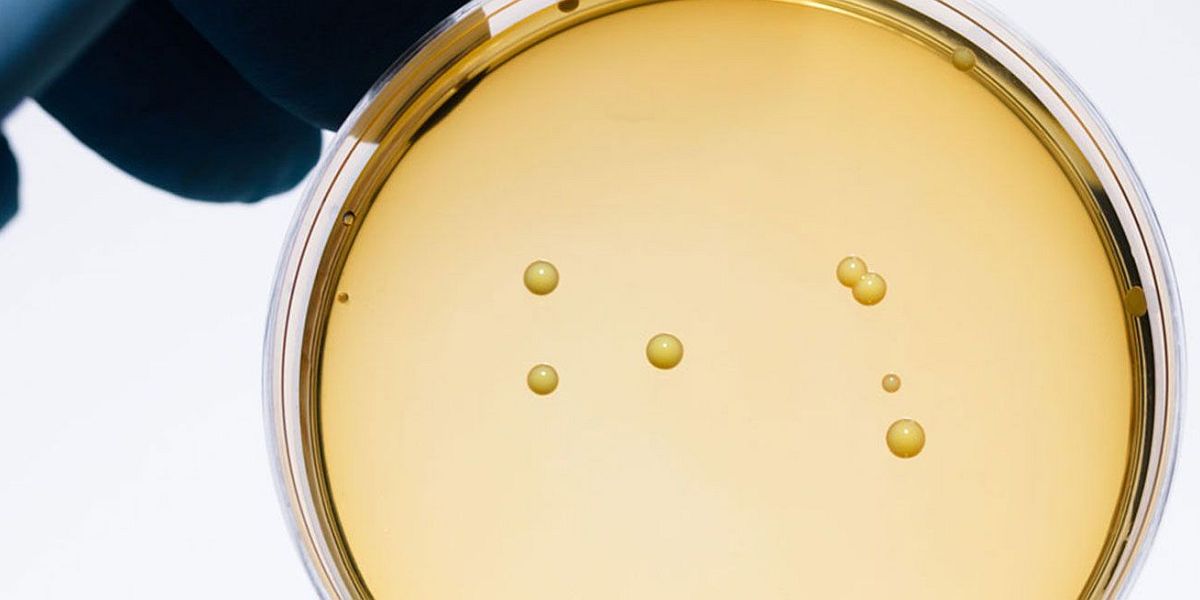

NiceLabel LMS
Bacterial Bioscience
How a food ingredients producer uses web printing to generate labels on demand for orders in SAP
NiceLabel web printing gets data from the SAP process order to generate labels in production and distribution
How to label 3,000 custom batches a day?
This global bioscience company supplies cultures, enzymes and probiotics to food and pharmaceutical industries. In all their 30 locations print labels for 3,000 orders a day in all for pouches, boxes, packaging and shipping. Theit label designers work Compliance, Legal, IT and Production to create and maintain label templates.
Their labelling system was 15 years old.
Problems
- No remote access
- No 24/7 IT support: risk of prolonged production delays)
- Validation of processes to FDA standards was difficult and costly.
- Label creation was cumbersome.
NiceLabel Solutions
- The SAP ABAP plug-in ensured quick implementation.
- Web Printing lets production generate labels on demand at any time from a process order on SAP.
- Local NiceLabel servers at the main plants in Europe and the USA ensure 24/7 availability when the main server is down.
- Variants (exact finished labels for each SKU) prevent any unauthorized change to label content for food and pharma production; operators only enter data like batch numbers.
Results
- Universal label templates and variants enabled a drastic reduction in label desgns.
- Label creation is easier and faster.
- Support is better with errors discovered sooner.
Downloads
Related Applications

Food ingredients supplier uses web printing to generate labels on demand for orders in SAP